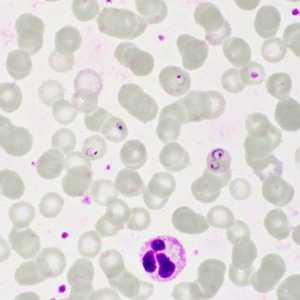
Figure E

Case #413 - February 2016
Case Description
A 20-year-old male from Ghana presented to a hospital with flu-like illness, hepatomegaly, thrombocytopenia, a low absolute lymphocyte count (ALC), an elevated absolute monocyte count (AMC), and lymphocyte reactive forms. A blood specimen was collected to perform the BinaxNOW® Malaria Rapid Diagnostic Test (RDT) and to prepare thick and thin blood smears to be stained with Giemsa and examined. Figure A shows the result of the RDT. Figure B shows an example of what was observed on a thick smear at 1000x magnification with oil; Figures C-I show what was observed on a stained thin blood smear at the same magnification. What is your diagnosis? Based on what criteria?

Figure A

Figure B

Figure C

Figure D
Figure E

Figure F

Figure G

Figure H

Figure I
Case Answer
This was a case of malaria caused by Plasmodium falciparum. The diagnostic morphologic features shown included:
- many ring-stage trophozoites in the absence of other stages on both the thick and thin smears.
- infected red blood cells (RBCs) that were normal sized.
- multiply-infected RBCs.
- appliqué forms.
- presence of malarial pigment (which ruled-out Babesia sp.).
The result of the BinaxNOW® test was positive and allowed for timely treatment of the patient. Figure A showed that the Control line was present, indicating that the test was valid. The test lines T1 and T2 were both present and, according to the test insert, is indicative that the specimen was positive for P. falciparum or possible mixed infection of P. falciparum and another species. It is highly recommended that microscopic examination of stained blood smears also be conducted for confirmation. In this case, based on the morphologic features observed, only P. falciparum was present and there was no indication of a mixed infections with another species.
More on: Malaria
Acknowledgements
This case and images were kindly provided by the Cadham Provincial Laboratory, Manitoba, Canada.
DPDx is an education resource designed for health professionals and laboratory scientists. For an overview including prevention and control visit www.cdc.gov/parasites/.
- Page last reviewed: August 24, 2016
- Page last updated: August 24, 2016
- Content source:
- Global Health – Division of Parasitic Diseases and Malaria
- Notice: Linking to a non-federal site does not constitute an endorsement by HHS, CDC or any of its employees of the sponsors or the information and products presented on the site.
- Maintained By:


 ShareCompartir
ShareCompartir